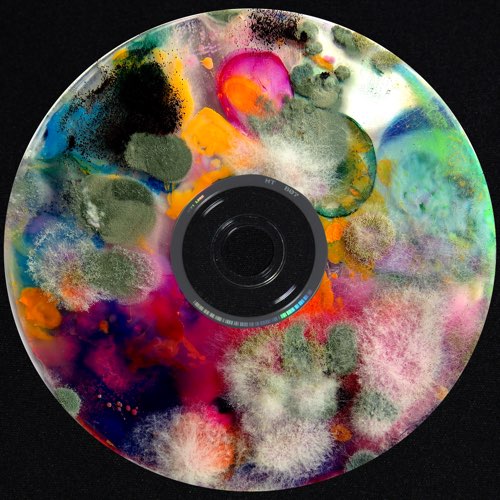
Boulevard Depo - Трасса 60 (feat. Jeembo) Boulevard Depo - Трасса 60 (feat. Jeembo)

Obladaet - Hella Players (feat. Jeembo)
Текст песни Obladaet - Hella Players (feat. Jeembo):
[Интро: OBLADAET]
808 Mafia
(А) Я, я
Skipass, you a fool for this one
Восемь-один-два, OBLA, JEEMBO (А-а), Mafia, Skipass (Pow, пр-р), а-а (А), (13-8-9-0) е (А)
[Куплет 1: OBLADAET]
У нас нет beefа, как веган, но в карманах котлеты (Pow)
У вас нет beefа, вы фейки, я в тебе вижу lameа (А-ха)
У меня есть пятак, как оценки, ведь чуть больше проблемы (А, pow, шлюха)
Сука, ты с улиц, как Кермит, dropаю шмот, за ним будут campить (Campить шмот)
Bimmer в greenе (Skrrt, skrrt), и я кручусь, как grinder (Skrrt-skrrt-skrrt)
JEEMBO, Skipass (Pow), PLAYERS CLUB EKIP (Салют Honsey)
На-Нахуй (Нахуй) лики (У-у) — stuffчик очень липкий (Po-Pow)
Убрал тебя (Е) — клининг, (Будто) мы на огромной льдине (Pow, а)
Компас на плече — потерян в Атлантиде (Это стонник)
Я вижу эти пирамиды, и мы крутим свитки (Fifty-fifty, я)
(Digiri-baow, baow) Я выдыхаю призрак (Ghosty), у-у меня нет выхода, но, как труба, есть выхлоп (Skrrt, skrrt)
[Бридж: OBLADAET]
(Skrrt, skrrt, skrrt) Я запрыгнул в Bimmer (Я)
(Я) Да, пять минут назад я запрыгнул в Bimmer (Bimmer)
(Я) Да, трахнул эту суку и уехал в Питер (Сразу)
Мне нужен новый перстень, слышал, что я должен выиграть
[Куплет 2: OBLADAET]
(Должен выиграть) Еду так быстро
Рядом карета превратилась в двенадцать
Как тыква, po-po (А), палят за мной (Bih, bih), но за мной не угнаться (Pow-pow, а)
Восемь-двенадцать, нахуй двенадцать
Я не больной, но я ща на лекарствах (Ха-а)
Ща тут задвигаешься, я не о танцах
Воняет так сильно — четыреста двадцать (Ho, ho, сглаз)
Вижу их, даже когда без мигалок (Pow-pow)
Я убит (K.O), камера не распознала (Е, е)
Семь-три-пять — высота будто скалы
Люблю эти галки, как Галкина Алла (Swoosh, whoosh)
Тебя могут пришить тут я не о тканях (Дизайнер)
Слышь, я бронирован, слово из стали
Ро-Розовый VVS на новом оскале
Полный bust down, я не опоздаю (Camp, camp, а-а)
[Куплет 3: JEEMBO]
Подо мной турбированый демон (Демон) — кузов цвета веном
Сине-белая эмблема корпорации umbrella (Бр-р)
Bitch, я выхожу на сцену, свежий дизель в моих венах (Ву-у)
Мы подкинем твоё тело, скажи спасибо, что целым (Окей, окей, окей)
J.J Guerilla, лучше держись за перила, ho (Pow)
Дымим, как кадило, под капотом злая сила, ho
Drop от Hella Hillz, и свежий stuff от игроков (Stuff)
Тут темнота между домов, в ней полный рот острых зубов (У-у)
[Бридж: JEEMBO]
Skipass на бите, плюс 808 Mafia (Pow)
Курим на Неве, камни на мне холодней кафеля (Pain, pain)
Что-то в моём stuffе, стиль до гроба — эпитафия (Smoke, smoke)
Ничего не придумал (Не), это моя биография (Не)
[Куплет 4: JEEMBO]
Белый rhino (Burr), фейки мимо (Pow)
Ветер в спину (Fashion), Джонни длинный (Длинный)
J.J. — хикки (Хикки), OBLA — киллер (Digiri-baow)
Loco, Питер (Питер) прыгнул в Bimmer (Ho)
(Эй) Нина в кобуре Bottega (Bottega)
Мы с ней Альфа и Омега (Альфа, Альфа)
Пока слабаки слетают с трека
Каждый день иду за stackом (Ха, pow)
Я собрал это, как Lego, ho (Ho, ho, ho)
Mp3zvuk.ru - музыкальный портал